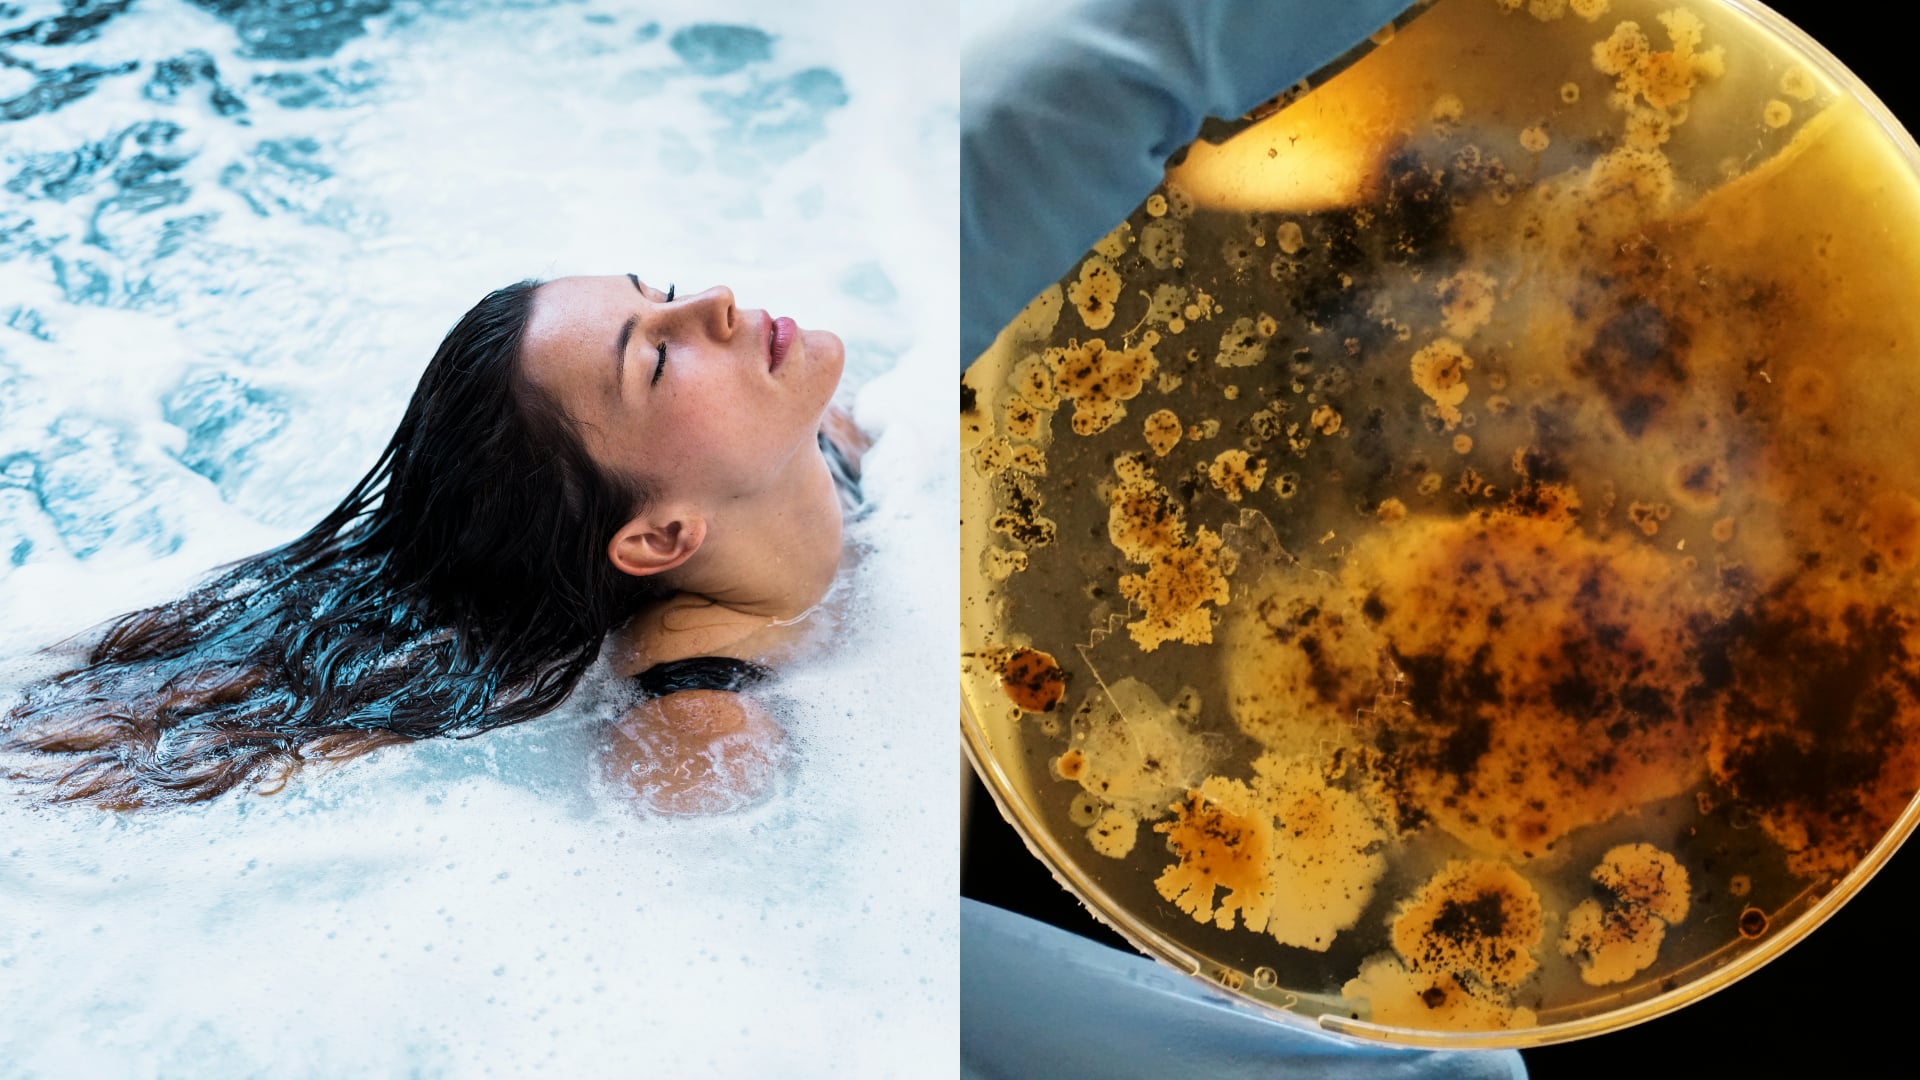
vírivka

V hotelovej vírivke v Demänovskej Doline hygienici potvrdili prítomnosť baktérie Legionella
- V Demänovskej Doline našli v hotelovej vírivke baktériu Legionella
- Štyria hostia sa nakazili, jedna žena zomrela
Vo vírivke v jednom z hotelov v Demänovskej Doline hygienici potvrdili prítomnosť baktérie Legionella. Pre TASR to potvrdila regionálna hygienička Iveta Triznová z Regionálneho úradu verejného zdravotníctva (RÚVZ) v Liptovskom Mikuláši.
Počas pobytu v hoteli sa baktériou mala podľa informácií denníka Nový Čas koncom mája nakaziť 65-ročná žena, ktorá neskôr zomrela.
Potvrdené prípady nákazy a úmrtie
Hovorkyňa RÚVZ Bratislava Katarína Nosálová pre TASR uviedla, že zo 45 osôb, ktoré sa zúčastnili na pobyte v Demänovskej doline, u štyroch osôb bola laboratórne potvrdená prítomnosť baktérie Legionella. V uvedenej súvislosti bolo zaznamenané aj jedno úmrtie.
„Mechanizmus prenosu u legionárskej choroby takmer výlučne spočíva vo vdýchnutí vodného aerosólu kontaminovaného uvedenou baktériou, napríklad z klimatizácie, pri sprchovaní alebo na kúpaliskách s vodnými atrakciami,“ priblížila Nosálová.
Reakcia hygienikov a opatrenia v hoteli
Odborní pracovníci RÚVZ v Liptovskom Mikuláši vykonali štátny zdravotný dozor v predmetnom zariadení. Prevádzkovateľovi zariadenia bola uložená povinnosť na bezodkladné vykonanie opatrení na zabezpečenie kvality a zdravotnej bezpečnosti pitnej vody, teplej vody a vody na kúpanie. „RÚVZ nariadil preventívne uzatvorenie rehabilitačnej časti a bazénovej časti. Na základe vyhovujúcich výsledkov RÚVZ 10. júla zrušil uložené opatrenia, s výnimkou vírivky,“ podotkla Triznová.
Prevádzkovateľ zariadenia vyšetroval kvalitu vody v bazéne v mesačných intervaloch. Podľa RÚVZ v Liptovskom Mikuláši všetky predložené výsledky vzoriek vybraných bazénov z mesiacov február až máj 2025 vyhoveli v stanovených ukazovateľoch.
Riziká baktérie Legionella
Legionely sú potenciálne patogénne mikroorganizmy, ktoré môžu predstavovať vážne zdravotné riziko. „Prirodzene sa vyskytujú v umelých aj prírodných vodných systémoch a v pôde. V umelo vytvorenom vodnom prostredí je ich prežívanie a rast podporený najmä použitím nevyhovujúcich konštrukčných a spojovacích materiálov či nedostatočnou údržbou vodovodných rozvodov a nedodržanou teplotou vody v nich, čo predstavuje zdravotné riziko,“ uviedol RÚVZ na svojom webe.
Čítaj viac z kategórie: Zo Slovenska










